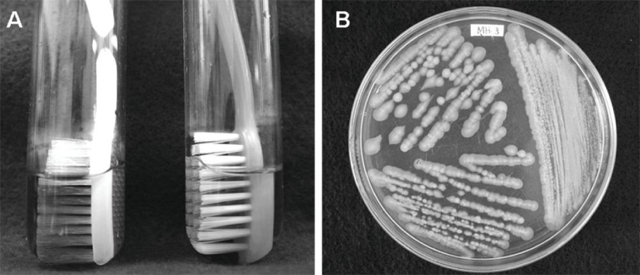

有没有想过,我们每天使用的牙刷可能是细菌和致病原的温床?马桶的细菌、家人的感冒病毒等有可能随牙刷进入我们的口腔。专家提醒大家要定期清洁和更换牙刷,以及检视存放牙刷的方式是否安全卫生。

BBC Future最近发表一篇讨论牙刷卫生的文章。文章引述多位科学家指出,牙刷的刷头像草丛,藏满数以百万计的细菌和真菌,还有多不胜数的病毒。随着牙刷耗损,埋藏污垢的接触面增加,而水、唾液、口腔皮肤细胞和食物残渣,以至牙刷存放的环境,都提供了有利细菌滋长的条件。
别以为未用过的牙刷便没有细菌污染。巴西圣保罗大学抽查40款购自当地商店的新牙刷,研究人员将牙刷头浸在0.5毫升的无菌食水中,21天后,47%样本受多种细菌污染,惟刷毛加上氯己定(漱口水成份)的样本不受污染。
负责该项研究的牙医教授柏查士(Vinicius Pedrazzi)说,在牙刷上找到的微生物包括黏液罗氏菌(Rothia denocariosa)、口腔链球菌(Streptococcaceae mitis)和放线菌属(Actinomyces)等,大部分都是人体口腔常见的无害细菌。不过,部分样本发现有引致蛀牙的口腔链球菌和葡萄球菌,以及令牙肉发炎或引起牙周病的菌。个别牙刷样本上有大肠杆菌等与肚泻和食物中毒有关的细菌,以及高抗药性和高毒力的肺炎克雷伯菌(Klebsiella Pneumoniae)。
大多数人将牙刷放在浴室,厕所马桶冲水或洗澡时溅出的水花,以至浴室窗外的空气,都可能是牙刷污染的源头。德国莱茵瓦尔应用科技大学(Rhine-Waal University)的微生物学家辛尔(Marc-Kevin Zinn)指出,浴室温暖而潮湿,水气里可能充满细菌和病毒,令牙刷容易受污染。另外,我们每次如厕后冲水,马桶溅起的水花可以散播到1.5公尺以外的地方,如果牙刷放近马桶,就有可能沾染到马桶里的污物。他提醒大家在冲厕时,避免吸入马桶溅出的微细水滴,以保障卫生和健康。

辛尔认为,从牙刷感染致病原的风险很低,惟免疫系统功能较弱的人要注意。他的研究团队将牙刷上的细菌作DNA排序,发现有少数细菌带有可抵御抗生素作用的基因,意味一旦感染了该类细菌,药物治疗的效果会较弱。意大利曾经有一项牙刷抽样检查发现,全数50支学生牙刷样本都含有抗药的细菌。
美国伊利诺州西北大学工程系的夏特文(Erica Hartmann)教授与她的研究团队曾经分析34个由公众提供的牙刷样本,仅找到极小量与粪便有关的细菌,反映肠道微生物离开人体后不能存活。她又说,牙刷上有一些噬菌体,只会感染细菌而对人无害,有助控制菌的数量。
怎样清洁和保养牙刷才安全卫生?坊间有多种牙刷杀菌方法。有人用紫外光消毒,有人将牙刷放进洗碗碟机或微波炉,也有人用威士忌浸牙刷。但专家表示,这些方法未有科学证据证实可以减少刷毛上的菌量。

专家建议,将牙刷头放在加入1% 醋的水,或用漱口水浸洗。牙刷头向上放置,让它自然风干,便可保持清洁。虽然感冒病毒和新冠肺炎病毒在空气中可存活长达48小时,但其结构在脱水后会破坏;引致蛀牙的菌可在牙刷存活8小时,但12小时后便开始死亡。
使用时间愈长的牙刷,含菌量愈高,辛尔的研究发现,牙刷经使用12星期后含菌量达至高峰。美国牙医协会建议大家每三至四个月更换牙刷,勿将牙刷头密封或放在柜里,因为潮湿不通风的环境会令细菌滋长。
有公司从牙膏着手。新西兰一间公司研制出益生菌牙膏,在牙膏加入唾液链球菌 (Streptococcus salivarius),以抑制坏菌生长和减少牙石,罗伊氏乳酸杆菌(Limosilactobacillus reuteri)则可以克制造成蛀牙的变型链球菌(Streptococcus mutans)。

































